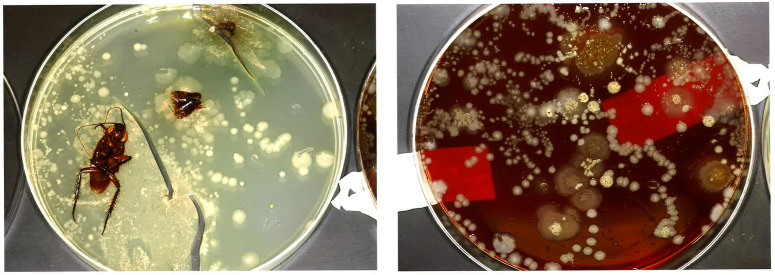

BROTE DE SUPERBACTERIAS EN LA UVI DE UN HOSPITAL POR INFESTACIÓN DE CUCARACHAS
30 Octubre, 2024
Es conocido que las cucarachas pueden transportar en su cuerpo más de 40 tipos de bacterias, además de otros patógenos como hongos, virus, parásitos y protozoos.
Habitualmente, estas bacterias contaminan los alimentos y son capaces de producir toxiinfecciones alimentarias.
Los insectos tienen un papel potencial en la transmisión de patógenos en los hospitales y su papel debe considerarse cuando se investigan los brotes.
En un estudio llevado a cabo en la Unidad de Cuidados Intensivos de un Hospital de Estado Unidos se ha descrito un brote de infección por la superbacteria Enterobacter cloacae (MRE) multirresistente durante un período de 20 meses.
Enterobacter Cloacae es un patógeno oportunista de ambientes hospitalarios, siendo el segundo bacilo Gram negativo más aislado después de Pseudomonas spp. Este microorganismo se encuentra habitualmente en infecciones de pacientes hospitalizados en Unidades de Cuidados Intensivos y en neonatología, con importantes enfermedades o que estén recibiendo terapia inmunosupresora. Causa del 6 al 11% de todas las infecciones hospitalarias.
Para frenar el brote, se tomaron las medidas habituales de prevención de infecciones como aislamiento de contactos, higiene de manos, equipamiento dedicado al paciente exclusivo, cultivos ambientales y control de plagas.

Un total de 25 pacientes se diagnosticaron por estar colonizados o infectados con MRE. En el laboratorio de microbiología, se vio la misma identidad de la cepa en los enfermos del brote y las cepas encontradas en las cucarachas mediante la electroforesis en gel de campo pulsado. (PFGE)
Las intervenciones estándar de prevención sanitaria no tuvieron un impacto en la resolución del brote hasta que se aplicó un adecuado control de plagas que erradicó las cucarachas presentes en la UCI.
Una vez que se implementaron medidas adicionales de control de plagas, el brote pudo controlarse y darse por finalizado.
Las cucarachas rara vez se han informado en hospitales como vectores de transmisión de enfermedades, pero este brote probablemente no sea una situación única.
Por todo ello, concluyen los autores de la publicación que es esencial en la investigación de brotes de infecciones hospitalarias sospechar de los insectos como vectores si se encuentran en las áreas donde se atiende al paciente e implantar un adecuado control de plagas con una empresa profesional.